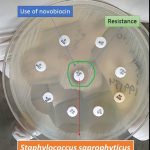
Use of novobiocin disk
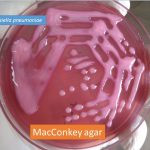
Klebsiella pneumoniae on MacConkey agar

Collection Group: Clinical Bacteriology
Use of Novobiocin Disk for Presumptive Identification of Staphylococcus saprophyticus
Use of Novobiocin Disk Novobiocin ( antibiotic) differentiation disk is...
Use of Novobiocin Disk Novobiocin ( antibiotic) differentiation disk is...
Klebsiella pneumoniae on MacConkey Agar and Its Details
Klebsiella pneumoniae on MacConkey Agar Klebsiella pneumoniae on MacConkey agar...
Klebsiella pneumoniae on MacConkey Agar Klebsiella pneumoniae on MacConkey agar...
Turicella Bacteria: Gram stain introduction, Principle, Procedure and Result Interpretation
 Turicella in Gram Stain Turicella otitidis in gram stain is...
Turicella in Gram Stain Turicella otitidis in gram stain is...
